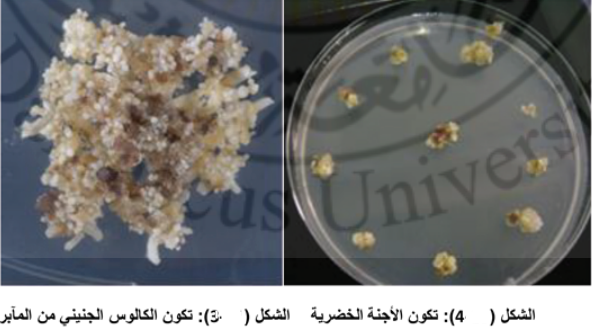

الفاكهة والاشجار المثمرة


نخيل التمر

النخيل والتمور

آفات وامراض النخيل وطرق مكافحتها

التفاح

الرمان

التين

اشجار القشطة

الافو كادو او الزبدية

البشمله او الاكي دنيا

التوت

التين الشوكي

الجوز

الزيتون

السفرجل

العنب او الكرمة

الفستق

الكاكي او الخرما او الخرمالو

الكمثري(الاجاص)

المانجو

الموز

النبق او السدر

فاكة البابايا او الباباظ

الكيوي


الحمضيات

آفات وامراض الحمضيات

مقالات منوعة عن الحمضيات


الاشجار ذات النواة الحجرية

الاجاص او البرقوق

الخوخ او الدراق

الكرز

المشمش

مواضيع عامة

اللوز

الفراولة او الشليك

الجوافة

الخروب(الخرنوب)

الاناناس

مواضيع متنوعة عن اشجار الفاكهة

التمر هندي

الكستناء

شجرة البيكان ( البيقان )

البندق


المحاصيل


المحاصيل البقولية

الباقلاء (الفول)

الحمص

الترمس

العدس

الماش

اللوبياء

الفاصولياء

مواضيع متنوعة عن البقوليات

فاصوليا الليما والسيفا

محاصيل الاعلاف و المراعي


محاصيل الالياف

القطن

الكتان

القنب

الجوت و الجلجل

محصول الرامي

محصول السيسال

مواضيع متنوعة عن محاصيل الألياف


محاصيل زيتية

السمسم

فستق الحقل

فول الصويا

عباد الشمس (دوار الشمس)

العصفر (القرطم)

السلجم ( اللفت الزيتي )

مواضيع متنوعة عن المحاصيل الزيتية

الخروع


محاصيل الحبوب

الذرة

محصول الرز

محصول القمح

محصول الشعير

الشيلم

الشوفان (الهرطمان)

الدخن


محاصيل الخضر

الباذنجان

الطماطم

البطاطس(البطاطا)

محصول الفلفل

محصول الخس

البصل

الثوم


القرعيات

الخيار

الرقي (البطيخ الاحمر)

البطيخ

آفات وامراض القرعيات

مواضيع متنوعة عن القرعيات

البازلاء اوالبسلة

مواضيع متنوعة عن الخضر

الملفوف ( اللهانة او الكرنب )

القرنبيط او القرنابيط

اللفت ( الشلغم )

الفجل

السبانخ

الخرشوف ( الارضي شوكي )

الكرفس

القلقاس

الجزر

البطاطا الحلوه

القرع

الباميه

البروكلي او القرنابيط الأخضر

البنجر او الشمندر او الشوندر

عيش الغراب او المشروم او الأفطر


المحاصيل المنبهة و المحاصيل المخدرة

مواضيع متنوعة عن المحاصيل المنبهة

التبغ

التنباك

الشاي

البن ( القهوة )


المحاصيل السكرية

قصب السكر

بنجر السكر

مواضيع متنوعة عن المحاصيل


نباتات الزينة والنباتات الطبية والعطرية

نباتات الزينة

النباتات الطبية والعطرية


الحشرات النافعة


النحل

نحل العسل

عسل النحل ومنتجات النحل الاخرى

آفات وامراض النحل


دودة القز(الحرير)

آفات وامراض دودة الحرير

تربية ديدان الحرير وانتاج الحرير الطبيعي


تقنيات زراعية

الاسمدة

الزراعة العضوية

الزراعة النسيجية

الزراعة بدون تربة

الزراعة المحمية

المبيدات الزراعية

انظمة الري الحديثة


التصنيع الزراعي

تصنيع الاعلاف

صناعات غذائية

حفظ الاغذية


الانتاج الحيواني


الطيور الداجنة

الدواجن

دجاج البيض

دجاج اللحم

امراض الدواجن


الاسماك

الاسماك

الامراض التي تصيب الاسماك


الابقار والجاموس

الابقار

الجاموس

امراض الابقار والجاموس


الاغنام

الاغنام والماعز

الامراض التي تصيب الاغنام والماعز


آفات وامراض النبات وطرق مكافحتها


الحشرات

الحشرات الطبية و البيطرية

طرق ووسائل مكافحة الحشرات

الصفات الخارجية والتركيب التشريحي للحشرات

مواضيع متنوعة عن الحشرات

انواع واجناس الحشرات الضارة بالنبات

المراتب التصنيفية للحشرات


امراض النبات ومسبباتها

الفطريات والامراض التي تسببها للنبات

البكتريا والامراض التي تسببها للنبات

الفايروسات والامراض التي تسببها للنبات

الاكاروسات (الحلم)

الديدان الثعبانية (النيماتودا)

امراض النبات غير الطفيلية (الفسيولوجية) وامراض النبات الناتجة عن بعض العناصر

مواضيع متنوعة عن امراض النبات ومسبباتها


الحشائش والنباتات الضارة

الحشائش والنباتات المتطفلة

طرق ووسائل مكافحة الحشائش والنباتات المتطفلة

آفات المواد المخزونة

مواضيع متنوعة عن آفات النبات

المكائن والالات الزراعية

مواضيع متنوعة عن الزراعة
زراعة المياسم وحبوب اللقاح
المؤلف:
د. خليل المعري
المصدر:
زراعة الانسجة النباتية وتقاناتها -الجزء النظري-
الجزء والصفحة:
ص 239-253
2023-04-26
3981
زراعة المياسم وحبوب اللقاح
تعد تقانة زرع حبوب اللقاح من تقانات زراعة الأنسجة النباتية المهمة المستخدمة في تربية النبات تهدف عملية زرع حبوب اللقاح الحصول على نباتات وحيدة الصيغة الصبغية وعند تضاعفها بالكولشيسين تعطي نباتات ثنائية الصيغة الصبغية، والتي تمثل سلالات نقية تدخل بشكل مباشر في برامج تربية النباتات الاقتصادية من أهم الأساسيات الضرورية في مجال تربية النبات هو الحصول على أكبر قدر من التباينات الوراثية من المصادر النباتية حتى يكون هناك مجال لإجراء عملية الانتخاب.
وقد وضع أول تقرير علمي عن إمكانية الحصول على نباتات أحادية من نبات الداتورة من قبل العالمين Guha and Maheshwari 1964 و 1966 وذلك عن طريق تكوين أجنة من حبوب اللقاح، وقد تمكن العالمان 1967,Bourgin and Nitsch من الحصول على نباتات أحادية من الدخان، وخلال الأعوام الأخيرة من الثمانينات أمكن الحصول على نباتات أحادية من الأرز، القمح، الذرة والكرنب والعديد من المحاصيل الأخرى. ولقد شجع هذا النجاح علماء التربية أن يعملوا جاهدين للحصول على نباتات متباينة من تلك النباتات الأحادية.
إن عملية الحصول على السلالات النقية بالطرائق التقليدية تحتاج عدة سنوات من العمل، في حين يمكن الحصول عليها بزراعة النسج بفترة زمنية قصيرة. يتم توفير الوقت والجهد عند استخدام الطرائق الحديثة يتم زراعة حبوب اللقاح أو المياسم في مرحلة محددة بعد الانقسام الميوزي في الأسدية عند تشكل الأعراس الذكرية، وحيدة الصيغة الصبغية وقبل عملية التلقيح. تم الحصول على نباتات احادية الصيغة الصبغية بتطبيق هذه التقانة في أكثر من 250 نبات من الفصائل التالية الباذنجانية - الوردية - الصليبية - والنجيلية وغيرها.
بعض التعاريف المرتبطة بالتقانة:
- الأندروجينيزيس Androgenesis: ويقصد بها زرع الأجزاء الزهرية المذكرة من الزهرة المياسم أو حبوب الطلع لتكوين سلالات وحيدة الصيغة الصبغية.
- الجينوجنيزيس Gynogenesis: ويقصد بها زراعة الأعضاء المؤنثة من الزهرة البويضات قبل الإخصاب، بعد الانقسام الاختزالي وقبل التلقيح بهدف الحصول على سلالات وحيدة الصيغة الصبغية.
- السلالة النقية Clone pure: وهي سلالات ثنائية الصيغة الصبغية وتكون الكروموزومات نقية ومتشابهة ومتطابقة بدون وجود أي اختلاف في توزيع الجينات بين الصبغيات الثنائية. وهذا ينطبق على كافة الصبغيات الثنائية.
- سلالة وحيدة الصيغة الصبغية Haloid: سلالة وحيدة الصيغة الصبغية تنشأ من خلايا حبوب اللقاح أو من البويضة المؤنثة قبل التلقيح. ويوجد سلالات n1 محدثة بزراعة النسج، كما يوجد سلالات وحيدة الصيغة الصبغية طبيعية تتواجد في بعض النباتات.
- السلالات وحيدة الصيغة الصبغية الطبيعية Spontaneous haploids: تميل بعض الأنواع النباتية لتشكيل بشكل طبيعي سلالات وحيدة الصيغة الصبغية، بنسبة قليلة جداً لا تتعدى واحد بالألف. كما هو الحال في نبات الأسبرج والقطن والفليفلة. ونميز الأنواع الآتية من السلالات الطبيعية:
1- النباتات متعددة الأجنة Polyembryonies مثل في الأسبرج بحيث يوجد جنینیں في البذرة واحد طبيعي ثنائي الصيغة الصبغية ويكون نموه جيد وجنين نموه ضعيف يكون وحيد الصيغة الصبغية وينشأ عادة من أنسجة البويضة الأم من خلية مساعدة بعد الانقسام الاختزالي وقبل التلقيح تتطور هذه الخلية وتشكل جنين 1 N.
2- أجنة semigamy: وهي أجنة طبيعية تتكون بشكل مختلط من الأعراس المذكرة والأعراس المؤنثة بعد نمو الأنبوبة الطلعية وقبل حدوث الإخصاب ويكون الجنين في هذه الحالة وحيد الصيغة الصبغية كما هو الحال في بذور القطن وتكون نسبتها ضعيفة لا تتجاوز 1 بالألف.
3- أجنة طبيعية تنشأ بشكل طبيعي من حبوب اللقاح أو البويضة قبل التلقيح تتطور وتشكل نباتات وحيدة الصيغة الصبغية، ونسبتها قليلة جداً.
طرق إنتاج النباتات الأحادية:
1- إنتاج نباتات أحادية من البويضات غير المخصبة: Gynogenesis
تنتج النباتات الأحادية عن طريق تنمية بويضة غير مخصبة بسبب تأخير عملية التلقيح، طريقة بديلة مناسبة للنباتات ذات العقم الذكري، ونجحت في الشعير ودوار الشمس وغيرها، وتستعمل خلايا غير مخصبة بالكيس الجنيني أو المبيض أو البويضات نفسها.
أشهر هذه الطرق Parthenogenesis إذ تتطور خلية البويضة غير المخصبة، نتيجة تأخير التلقيح، أو بالتلقيح الكاذب بحبة لقاح بها خلل كنتيجة للمعاملة بالأشعة المؤينة أو بحبة لقاح غريبة قد تكون من النوع نفسه لكنها لا تحدث الإخصاب.
تعد الأبحاث المتاحة عن طريقة Gynogensis قليلة نسبياً، وذلك لصعوبة تطبيقها في الكثير من النباتات بالمقارنة مع زراعة المتك، تمتاز النباتات الأحادية بالقصر وصغر حجم الأوراق خاصة، النصل، وزيادة الثمار الصغيرة بسبب عدم تكوين البذور، وربما يشاهد عدد من الأوراق والأزهار الغير كاملة التكوين، أو اندماج أكثر من ورقة أو زهرة.
2- إنتاج النباتات الأحادية من حبوب اللقاح Androgenesis
تفيد زراعة المتوك Anther Culture في إنتاج نباتات أحادية من حبوب اللقاح من خلال تكوين الأجنة Pollen Embryogenesis، أو من خلال تكوين الكالوس Pollen Callusing. ويجب أن تؤخذ المتوك من نباتات حديثة الإزهار ويكون ذلك في مرحلة معينة من تكوين حبوب اللقاح قبل تفتح الزهرة. ويعود السبب في أخذ البرعم الزهري صغير وغير متفتح تحت ظروف إضاءة جيدة حتى تكون حبوب اللقاح غير ناضجة وفي مرحلة مناسبة للزرع.
أهمية مزارع المتوك وحبوب اللقاح:
ترجع أهمية هذه المزارع إلى الحصول على نباتات أحادية المجموعة الكروموسومية إما من خلال تكوين الأجنة أو تكوين الكالوس ويفيد هذا الآتي:
- تستخدم النباتات الأحادية في الحصول على سلالات ثنائية نقية من المحاصيل الخلطية التلقيح وذلك بمعاملتها بالكولشيسين. ويمكن استخدامها مباشرة في برنامج تربية النبات.
- تفيد مزارع المتوك في التعرف على الطفرات المنتخبة بسهولة.
- تستخدم زراعة المتك وحبوب اللقاح في الدراسات السيتولوجية المتعمقة.
- تفيد في دراسة آلية تكون نباتات كاملة من خلية او حبة طلع والعوامل التي تؤثر في تكوين الأجنة الخضرية من حبوب الطلع.
- يمكن الحصول على سلالات متباينة وراثياً عن طريق زراعة المتك وحبوب اللقاح من خلال تكوين الكالوس وتجديده، ويتم الحصول على سلالات مهمة يمكن الاستفادة منها في برنامج التحسين الوراثي. فقد تم إنتاج سلالات من حبوب الطلع ذات إنتاجية عالية من المواد الفعالة.
- تفيد النباتات الأحادية في الحصول على مختلف حالات التعدد الكروموسومي الغير تام.
طريقة زراعة المتك:
- تنزع المتوك المغلقة التي تحتوي على حبوب اللقاح غير الناضجة وهي ما تزال في حالة انقسام (بعد الانقسام المنصف وقبل أول انقسام خيطي).
- تؤخذ البراعم الزهرية من نباتات مزروعة في بيت زجاجي، تعقم البراعم الزهرية، وتفصل المتك بعناية من البراعم الزهرية.
- توضع المتوك المعقمة في بيئة مغذية معقمة ويشق المتك من الجانب باستخدام مشرط حاد ومعقم وتؤخذ الأسدية وتوضع في طبق بتري معقم، ويزال الخيط بعناية لتبقى المتوك فقط، ويجب أن تكون عملية شق المتوك بعناية حتى لا يحدث ضرر، لأن تجريحها يحفز غالباً تكوين كالوس من خلايا جدر المتوك وهي خلايا ثنائية.
وبعد شق المتوك بعناية تنتشر حبوب اللقاح على سطح البيئة الصلبة، كما يمكن زراعتها في بيئة سائلة وتحفظ على هزاز بطيء.
1- شروط تحضين مزارع المتوك:
تحضن مزارع المتوك أو حبوب اللقاح في حاضنات ذات كثافة ضوئية (5000- 10000لوكس) والفترة الضوئية 16 ساعة ودرجة حرارة من 22-28م. تتحول جدر المتوك تدريجياً للون البني ثم تتفتح خلال 3-8 أسابيع على حسب النوع النباتي وذلك بسبب الضغط الداخلي للكالوس المتكون من حبوب اللقاح أو بسبب النبيتات التي تنمو منها، ثم تفصل هذه النبيتات أو النموات الخضرية المتكونة عن الكالوس بعد أن يصل طولها إلى 3-5مم، وتنقل إلى وسط مناسب للنمو الجذري.
تنقل النباتات المجذرة إلى أصص صغيرة تحتوي على خليط من التربة والبيتموس، وتغطى هذه الأصص بأكياس بلاستيك وتوضع في صوبة رطبة، وبعد أسبوع ترفع الأكياس البلاستيكية وبعد أسبوعين من ذلك تنقل النباتات إلى أصص أكبر حتى تصل إلى مرحلة الإزهار والنضج وهذه النباتات تكون أحادية، ويمكن تحويلها إلى نباتات ثنائية باستخدام الكولشيسين.

الشكل (1): زراعة المتك وحبوب اللقاح لإنتاج نباتات هابلويد
2- مثال تطبيقي:
زراعة المآبر:
يعتبر نبات التبغ النبات النموذجي لزراعة المآبر وحبوب اللقاح وبالتالي يعتبر البروتوكول التالي هو البروتوكول الأساسي لزراعة المآبر في نبات التبغ:
- يتم أخذ المآبر غير الناضجة التي تحوي على حبوب اللقاح بعد الانقسام المنصف، وقبل أول انقسام خيطي إذ تعتبر هذه المادة المثالية لاستحداث الكالوس.
- تنقل البراعم الزهرية غير المتفتحة إلى جهاز العزل الجرثومي (دون القيام بغسلها بالماء والصابون لأنها أجزاء دقيقة جداً)، كل برعم زهري يحتوي على 5 سبلات - 5 بتلات - 5 أسدية.
- يتم إجراء تطهير سطحي للبراعم غير المتفتحة بغمرها بالكحول الإيتيلي 70% لمدة 10 ثواني ثم تنقل إلى محلول هيبوكلوريت الصوديوم تركيز 2%، ثم تغسل بالماء المقطر المعقم 3 مرات لإزالة آثار المواد المستخدمة في التعقيم.
- البراعم الزهرية في نبات التبغ يتم جمعها، وهي غير متفتحة بعد 3-4 أشهر من الزراعة، ويتم قياس طول المآبر، وكذلك طول البراعم، إذ يتم انتقاء براعم بطول 17-25 ملم (1-2.5 سم) وتستبعد البراعم التي بدأت بالتفتح.
- لاستخلاص المآبر تؤخذ البراعم، ويجرى قطع طولي باستخدام المشرط، ثم يتم استخراج المآبر ويتم فصل الخيط السدوي عن السداة (ثم نعمل شق في السداة لإخراج حبوب الطلع).
- يجب لفت النظر إلى ضرورة عدم حدوث أي ضرر على مستوى المئبر، وذلك حتى لا يتكون الكالوس، لأنه قد لا يكون مطلوباً لذلك يجب استبعاد الأجزاء المتضرة أثناء الزراعة.
تؤخذ المآبر وتوضع في ظروف ظلامية بزراعتها على بيئة مناسبة (MS) الصلبة أو بيئة White أو (Nitsch and Nitsch).
- تنقل الخزعات المزروعة إلى الحاضنة وبعد 4 أسابيع تتطور المآبر وتعطي أجنة وبعدها تتطور الأجنة وتعطي نباتات كاملة قد تكون أحادية الصيغة الصبغية او ثنائية الصيغة الصبغية.
- في بعض الحالات قد تتطور المآبر وتعطي نسيج كالوس، حتى مراحل متقدمة من التكشف. يتم فحص الكالوس فقد تحوي على خلايا 1 N و 2 N وخلايا ثلاثية الصيغة الصبغية.
شروط التحضين:
ظلام، حرارة 24 - 28 م، فترة ضوئية 14 ساعة/ يوم، شدة ضوئية 2000 لوكس.
- بعدها تؤخذ النباتات بطول 5 سم وتنقل إلى بيئة آجار مغذية جديدة بعد غسل قواعد الجذور بالماء الجاري ونضعه في ظروف حرارة 27 م وفترة ضوئية 16 ساعة/ يوم، شدة ضوئية 1600 لوكس ورطوبة 75%.
- ثم تتم عملية تقسية هذه النباتات بفتح أنابيب الاختبار، وسحب هذه النباتات من البيئة فردياً، وتغسل قواعد الجذور بالماء المقطر المعقم (3 مرات)، وتوضع في أصص صغيرة تحوي بيتموس معقم، ويتم تغطية النباتات بمادة بلاستيكية شفافة ويثقب الكيس (3-2 ثقوب) للتهوية، ثم نزيد عدد الثقوب إلى (4-5 ثقوب) بعد أسبوع ثم بعد أسبوع آخر ننزع الكيس، وبعد 4 أسابيع تنقل النباتات لأصص أكبر حجماً وتنزع الأكياس نهائياً، ويجب إجراء العد الكروموزومي لمعرفة فيما لو كان النبات أحادياً أو ثنائي الصيغة الصبغية.
وقد تم زراعة المآبر في بعض أصول العنب وخاصة بـ41 بدءاً من البراعم وتوضح الأشكال (2) شكل البرعم الزهري في العنب. تم أخذ المآبر وزراعتها. بعد فترة من الزمن كونت كالوس جنيني كما هو موضح بالشكل (3).
نقل الكالوس الجنيني إلى وسط جديد لتشكيل الأجنة الخضرية كما هو موضح بالشكل (4). وقد تم الحصول على أجنة خضرية من زراعة المآبر التي نقلت إلى وسط إنبات حيث نمت الأجنة وكونت نباتات كاملة كما هو موضح بالشكل (5).

زراعة حبوب الطلع:
يمكن زراعة حبوب اللقاح بطريقتين:
1- الطريقة الأولى:
الطريقة المتبعة هنا تصف زراعة حبوب اللقاح المعزولة من التبغ، هذه التقانة تعد البروتوكول الرئيسي لزراعة حبوب اللقاح وتتضمن المراحل الآتية:
- اختيار براعم الأزهار المناسبة غير المتفتحة، وتعقيم حبوب اللقاح المعزولة بدون الخيط السدوي.
- يوضع حبوب اللقاح في وعاء معقم صغير يحوي 20 مل من البيئة السائلة الأساسية (MS أو White أو Nitsch and Nitsch).
- ثم تجمع حبوب اللقاح على جانب الكأس المعقم بواسطة مكبس زجاجي (حقنة) لسحبها واستخراجها.
- بعد ذلك تتم فلترة حبوب اللقاح المتجانسة عبر منخل نايلون (قطر فتحاته 40-60 μ) لإزالة حبوب اللقاح المحطمة.
- حبوب اللقاح التي تم ترشيحها يتم تثفيلها باستخدام قوة الطرد المركزي بسرعة منخفضة (500-800 دورة في الدقيقة) لمدة 5 دقائق.
- تستبعد المواد الطافية (حطام حبوب اللقاح)، وتنقل حبوب الطلع السليمة لوسط سائل جديد، وتغسل مرتين بإعادة التثقيل، وتنقل إلى بيئة سائلة جديدة.
- أخيرا تخليط حبوب اللقاح في الحجم المقاس من الوسط السائل الأساسي لتكون الكثافة بحدود 40000 حبة بالمل. يؤخذ 2.5 مل من معلق حبوب اللقاح وتنشر طبق بتري، تنمو حبوب اللقاح بشكل أفضل في الوسط السائل لكن إن كان من الضروري يمكن أن تنمو بزراعتها في وسط صلب يحوي كمية قليلة من الاجار، كل طبق من أطباق البتري يغلق بواسطة شرائط Cello لتجنب الجفاف.
- تحضن أطباق البتري على درجة حرارة 27-30 م تحت كثافة ضوئية منخفضة من الضوء الأبيض (LUX,500, 16hr)
- يمكن أن يلاحظ تشكل الأجنة الفتية بعد 30 يوماً وهذه الأجنة ستعطى عندما تنمو نباتات أحادية الصيغة الصبغية.
- النباتات أحادية الصيغة الصبغية تحضن على درجة حرارة 27-50 م (LUX22000 16) ثم تنقل هذه النباتات إلى التربة كنباتات أحادية الصيغة الصبغية.
مقارنة بين زرع المتك وزرع حبوب اللقاح:
تعد طريقة زراعة المآبر طريقة سهلة، سريعة، عملية، وجود جدار المآبر يعطي فرصة لنمو حبوب اللقاح بشكل جيد من مشاكلها نسبة النباتات وحيدة الصيغة الصبغية تكون قليلة لأنه يوجد خلط بين النباتات المتكونة من حبوب الطلع مع النباتات المتكونة من جدار المآبر، وهي إما تكون ثنائية أو مختلفة الصيغة الصبغية.
تعطي زراعة حبوب اللقاح نباتات وحيدة الصيغة الصبغية بشكل أعلى من زراعة المتك، لا توجد مشكلة وجود الجدار في المتك، وتكون نسبة النباتات الثنائية الصيغة الصبغية أو المختلفة أقل من زراعة المتك. كما تكون نسبة تطور الخلايا إلى أجنة عالية. وأخير نسبة الكالوس المتكونة في زراعة حبوب اللقاح قليلة.
العوامل المؤثرة في زراعة المتك وحبوب اللقاح:
توجد العديد من العوامل التي تؤثر في زراعة المتك وحبوب اللقاح، وتختلف استجابة المتك بحسب الأنواع النباتية، ومن أهم العوامل المدروسة نذكر:
1- درجة تطور حبوب اللقاح في المتك عند الزراعة: يعد عامل تطور حبوب اللقاح من أهم العوامل التي تعطي نتائج إيجابية في زراعة المتك وحبوب اللقاح. البداية لابد من إعطاء فكرة على كيفية تطور حبوب اللقاح في المتك. تشمل مرحلتين:
- المرحلة الأولى: تشكل الخلايا وحيدة الصيغة الصبغية Microsporogenesis، وتتم من الخلايا الأم لحبوب اللقاح، ثنائية الصيغة الصبغية تقوم بالانقسام الاختزالي، وتشكل في نهاية المطاف أربع خلايا وحيدة الصيغة الصبغية.
- المرحلة الثانية: تطور الخلايا وحيدة الصيغة الصبغية، وتشكيل حبوب الطلع الناضجة Microgametogenesis تخضع للانقسام الميتوزي 1 و 2 لتشكيل حبوب اللقاح الناضجة والتي لها قدرة على التلقيح والإخصاب. تحوي حبوب الطلع على نواتين وحيدة الصيغة الصبغية.
يختلف الموعد المناسب لزرع حبوب اللقاح، وهي بشكل عام بعد الانقسام الميوزي، وقبل نضج حبوب اللقاح، كما هو موضح بالشكل (6). ففي الفصيلة النجيلية من المفضل زراعة المتك وحبوب اللقاح بعد تكوين الأعراس في المرحلة الأولى وقبل الانقسام الميتوزي الأول، وفي التبغ في مرحلة الانقسام الميتوزي الأول والثاني، وفي البيتونيا عند نضج 90% من حبوب اللقاح في المتك ( 1980 ,Margara ).
وقد أوضحت التجارب بأن عامل درجة تطور المتك من أهم العوامل التي تؤثر في استجابة المتك لتكوين الأجنة وإعطاء نباتات أحادية الصيغة الصبغية في العديد من الأنواع النباتية مثل القرنفل الصيني Fu et al., 2008 ) Dianthus chinensis ).
2- تعريض المتك للصدمات قبل زرعها:
يتم تعريض المتك قبل زرعها داخل الأنابيب إلى بعض الصدمات مثل درجة حرارة منخفضة كما هو الحال في القمح والتبغ. كما يمكن تعريض المتك إلى درجات حرارة مرتفعة فترة من الزمن تزيد من استجابة بعض الأنواع وتزيد في نسبة النباتات وحيدة الصيغة الصبغية الناتجة كما في نبات الكولزا Colza.
تعمل الصدمة الحرارية المنخفضة او المرتفعة إلى خلل في الانقسام الميتوزي في حبوب الطلع قبل نضجها مما يزيد من استجابتها بعد الزرع، وتزيد في نسب نباتات 1 N.
في نبات التبغ، لوحظ عند تعريض المتك لدرجات حرارة منخفضة 5 م لمدة 72 ساعة أدى إلى تكون أجنة بنسبة 58% في المتك المزروعة، وقد تم الحصول على نتائج مماثلة في نبات فول الصويا (2004 ,.Rodriguez et al).
وفي نبات اللفت عند تعريض المتك لدرجات حرارة مرتفعة حوالي 35م لمدة 24 ساعة زاد في نسبة تكون الأجنة من زراعة المتك.
3- تأثير الإضاءة: تلعب الفترة الضوئية والشدة الضوئية دورا في نسبة استجابة المتك للنمو وتكوين الأجنة. فقد أوضحت بعض التجارب التأثير الإيجابي لطول النهار القصير، والشدة الضوئية الكثيفة في تكوين الأجنة في زراعة المتك وحبوب اللقاح.

الشكل 6: مراحل تطور حبوب اللقاح وانقسامها لتحديد الموعد المناسب لزراعتها
4- تأثير عمر النبات الأم وفترة الإزهار: كلما زاد عمر النبات الأم قلت استجابة المتك للنمو وتكوين الأجنة، كما لوحظ أخذ المتك من نباتات في بداية الإزهار تكون استجابتها عالية للنمو، وتقل عند أخذ المتك من أزهار في نهاية فترة الإزهار.
5- تأثير عوامل الوسط المغذي: يلعب تركيب الوسط المغذي دوراً مهماً في استجابة المتك وحبوب اللقاح.
- تركيز السكروز في الوسط تحتاج بعض الأنواع النباتية إلى إضافة تراكيز عالية من السكروز أعلى من 80 غ /ل في الوسط المغذي مثل بعض أنواع الفصيلة النجيلية، وبعض الأنواع تحتاج إلى تراكيز خفيفة جداً 20 غ/ل مثل بعض أنواع الفصيلة الباذنجانية والفصيلة الزنبقية.
- تركيز الهرمونات النباتية في الوسط: لوحظ إضافة الأوكسين D2,4 إلى الوسط المغذي بتراكيز 1 مغ/ل يزيد من استجابة المتك وحبوب اللقاح، للانقسام الخلوي ويزيد من تطورها كما هو الحال في الفصيلة الصليبية والنجيلية. بينما لوحظ استجابة جيدة في بعض الأنواع النباتية عند استخدام تراكيز خفيفة من الأوكسين كما هو الحال في بعض أنواع الفصيلة الباذنجانية.
- إضافة الفحم المنشط: لوحظ عند إضافة الفحم المنشط إلى الوسط المغذي يزيد في نسبة تكون الأجنة الخضرية في زراعة حبوب اللقاح لبعض الأنواع النباتية مثل البطاطا والرز والتبغ. يعمل الفحم المنشط على امتصاص مثبطات النمو المفرزة في الوسط مما يؤدي إلى زيادة استجابة المتك وحبوب اللقاح المزروعة للنمو والتطور.
تقانة مضاعفة النباتات وحيدة الصيغة الصبغية Doubled Haploids:
تعد تقانة مضاعفة النباتات وحيدة الصيغة الصبغية إحدى التقانات الحديثة والتي يتم بوساطتها الحصول على سلالات نقية. والتي استخدمت في برامج تربية النبات في العديد من المحاصيل والنباتات البستانية. يتم الحصول على سلالات نقية بهذه الطريقة خلال سنة تقريبا، بينما في البرامج التقليدية عن طريق التلقيح الذاتي، تحتاج عدة سنوات إلى عشرات السنين في الأشجار المثمرة. ولابد من التمييز بين النباتات ثنائية الصيغة الصبغية والنباتات مضاعفة الهابلويد، في كلا الحالتين النباتات ثنائية الصيغة الصبغية، لكن في الحالة الأولى تحمل الصبغيات مورثات متشابهة أو مختلفة في كل زوج من الصبغيات، اما في النباتات مضاعفة الهابوليد تكون الصبغيات وترتيب المورثات متشابهة تماما Homogenous genome. تعد السلالات مضاعفة الهابوليد اكثر فاعلية في برنامج التهجين بغرض الحصول على أصناف جديدة ( 2016,Rahman and Michalak de Jimenez )، وتستخدم هذه التقانة في برنامج تربية النباتات بشكل روتيني مثل برنامج تحسين نبات الكانيولا ( 2007 ,.Xu et al )، ولابد من الإشارة أن استخدام هذه التقانة تعطي هجن نقية 100 %، كما تقصر البرنامج الزمني لبرنامج التربية، وتستخدم النباتات مضاعفة الهابلويد في الدراسات الوراثية وفي تطوير المعلمات الجزيئية.
تسمح تقانة زراعة حبوب اللقاح بإدخال الجينات بإحدى طرائق الهندسة الوراثية. وتسمح تقانة مضاعفة الهابلويد في تثبيت الجين المدخل في الصبغيات وتصبح النباتات المعدلة وراثيا أكثر ثبات وهذا تكون نتائج التعديل الوراثي أكثر فاعلية. ففي القمح تم إدخال مورثة زيادة التحمل للملوحة ( HVI1 ) عن طريق حبوب اللقاح وتم تثبيت هذه الصفة بتقانة HVII مضاعفة الهابلويد في الصبغيات المتشابهة ( 2011,Chauchan and Kurana .).
2- بروتوكول إنتاج نباتات مضاعفة الهابلويد:
سيتم وصف التقانة من خلال مثال على نبات اللفت Brassica napus وفق الخطوات الآتية:
1- تؤخذ البراعم الزهرية من نباتات جيدة النمو ومرباة داخل بيت زجاجي، وتنقل النباتات إلى غرفة نمو عند بدء الإزهار على درجة حرارة 15م نهارا / 10 م ليلاً و 16 ساعة إضاءة، وتترك لمدة أسبوع حتى موعد أخذ البراعم الزهرية في مرحلة بعد الانقسام الاختزالي وقبل الانقسام الميتوزيك ( الشكل 6 ). ويمكن التعرف وتحديد فترة أخذ البراعم من خلال تحديد حجم البراعم.
2- تعقم البراعم الزهرية ثم تستخلص حبوب اللقاح في وسط سائل، ويراعى عند التعقيم واستخلاص حبوب اللقاح أن تكون درجة حرارة المحاليل منخفضة حوالي 4 م.
3- تزرع حبوب اللقاح بتركيز 40000 خلية بالمل، في وسط مغذي سائل مع إضافة الكولشيسين بمعدل 200 ميكرومول لكل 10مل من الوسط الحاوي على الميكروسبور.
4- توضع خلايا الطلع المزروعة لمدة 48 ساعة بالظلام في حاضنة على درجة حرارة مرتفعة 32 م.
5- يغسل مستخلص حبوب اللقاح بإضافة نفس الوسط المغذي لاستبعاد الكولشيسين ويثقل، ويؤخذ الراسب الحاوي على حبوب اللقاح ويوضع في الظلام لمدة 12 يوما على درجة حرارة 22م وذلك بعد إضافة وسط مغذي سائل جديد. يجب في كافة المراحل المحافظة على عقامة ونظافة العمل، وبعدها تنقل إلى وسط جديد لمدة 12-20 يوما على أن يتم تبديل الوسط المغذي السائل مرة كل أسبوعين وفي نهاية هذه المرحلة تكون الأجنة قد تكونت.
6- تنقل الأجنة إلى وسط صلب لتنمو وتشكل نباتات كاملة، وهذه الفترة تحتاج من شهر حتى ثلاثة أشهر، يتم تعريض الأجنة لدرجات حرارة منخفضة 4 م لمدة 10 أيام، ثم تنقل إلى غرفة النمو على درجة 27 م لمتابعة تطورها حتى تصبح جاهزة للنقل إلى الظروف الطبيعية.
7- بعد ثلاثة أشهر من النقل النباتات مضاعفة الهابلويد تنمو بشكل طبيعي وتزهر وتكون بذور، أما النباتات الهابلويد يكون نموها ضعيفاً وتنمو بشكل غير طبيعي ولا تزهر وإذا أزهرت لا تكون بذوراً. وهنا تتوجب دراسة حالة تقييم للسلالات الناتجة للتمييز بين النباتات الهابلويد من النباتات مضاعفة الهابلويد.
8- كما يمكن التعرف على محتوى النباتات بشكل مبكر فيما إذا كانت هابلويد أو مضاعفة الهابلويد أو متعددة العدد الكروموزومي من خلال الدراسات السيتولوجية والتي عن طريقها يمكن معرفة عدد الكروموزومات في النباتات الناتجة ( Rahman and Michalak de Jimenez,2016).
ولابد من الذكر اخيراً بأن كافة العوامل التي تؤثر في زراعة المتك وحبوب اللقاح تؤثر في إنتاج النباتات مضاعفة الهابلويد، كما يمكن استخدام مواد أخرى غير الكولشيسين في مضاعفة الصبغيات مثل (trifluralin, oryzalin, and amiprophosmethyl (APM)، وهي مبيدات عشبية.
وقد تمكن فريق فرنسي من الحصول على نباتات مضاعفة الهابلويد في الإجاص وبمعاملة النموات الغضة بوسط مغذي سائل والمضاف له الأوريزالين بتركيز 300 ميكرومول لمدة 48 ساعة قبل نقلها الى نفس الوسط الخالي من مادة الاوريزالين.
ولابد من الاشارة بان هذه التقانة مستخدمة بشكل تجاري في انتاج السلالات النقية في العديد من برامج تربية النبات، وانتاج الاصناف التجارية، وفي برامج انتاج بذار النباتات البستانية وانتاج الهجن.
الاكثر قراءة في الزراعة النسيجية
اخر الاخبار
اخبار العتبة العباسية المقدسة
الآخبار الصحية

قسم الشؤون الفكرية يصدر كتاباً يوثق تاريخ السدانة في العتبة العباسية المقدسة
"المهمة".. إصدار قصصي يوثّق القصص الفائزة في مسابقة فتوى الدفاع المقدسة للقصة القصيرة
(نوافذ).. إصدار أدبي يوثق القصص الفائزة في مسابقة الإمام العسكري (عليه السلام)